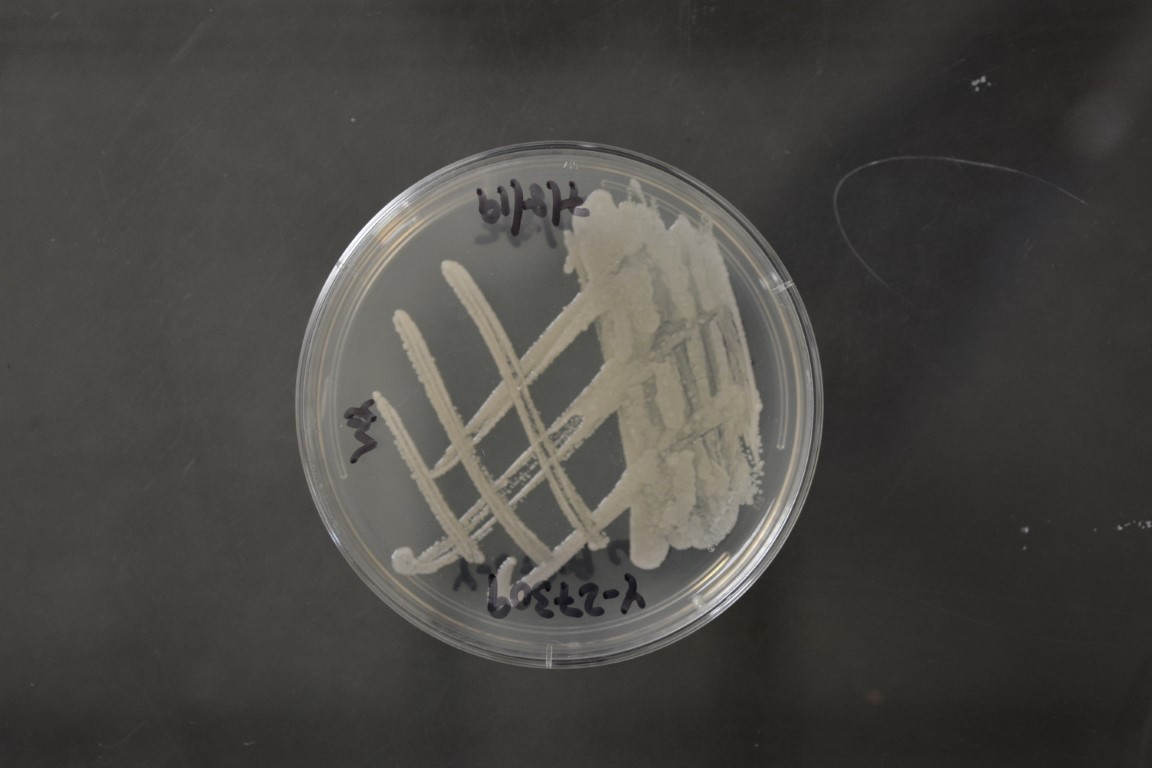

Tetrapisispora iriomotensis
NRRL Y-27309(Type Strain)
Accession numbers in other collections:CBS 8762=IFO 10929=JCM 10810=U97-101-2
Source:K.Mikata,IFO,Osaka,Japan
Isolated from(substrate):SL,soil
Substrate location:Iriomote Island,Japan
Genetic info:Robnett PCR#A315.GenBank:D1/D2(AB016506).
Growth media:Yeast Extract-Malt Extract-Peptone-Glucose(YM for yeasts)(number 6)
Optimum growth temperature:25C
Strain images:
NRRL_Y-27309_6.JPG

Comments:Int J Syst Bacteriol 49:1915-1924(1999).